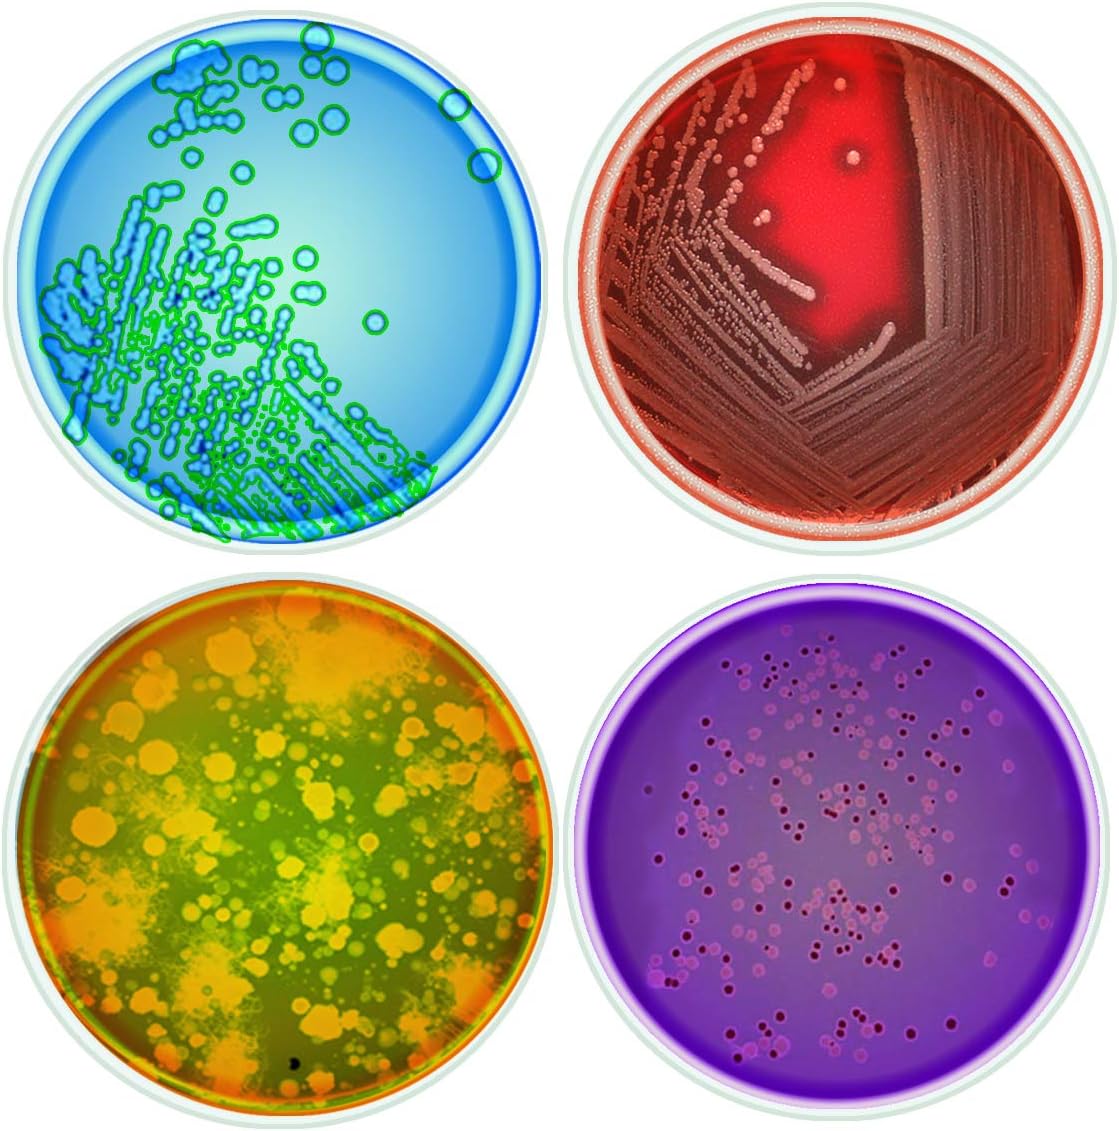
Gift It Right Set Of 4 Science Petri Dish 10cm Glass Coasters Can Be Used For Chemistry Mug Chemical Flask Science Lab Beaker Nerdy Gift For A Science Geek, Chemist, Scientist Or Chemistry Teacher
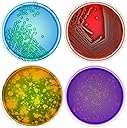
Thumbnail 1

🧬 Elevate your coffee break with a dash of science and style!
The Gift It Right Set of 4 Science Petri Dish Glass Coasters features heat-tempered glass with petri dish imprints in four distinct colors. Designed for durability and daily use, each coaster includes rubber feet to protect surfaces. Perfect for science enthusiasts, these coasters accommodate mugs, beakers, and flasks, making them a functional and stylish addition to any kitchen or home bar.
| ASIN | B009L6CZNY |
| Brand | Giftgarden |
| Color | multi |
| Date First Available | 30 June 2020 |
| Item Weight | 49.9 g |
| Material | Glass |
| Model Number | Strawb GG |
| Product Dimensions | 10 x 10 x 1 cm; 49.9 g |
| Special Features | Petri Dish imprint |
Trustpilot
2 weeks ago
3 weeks ago